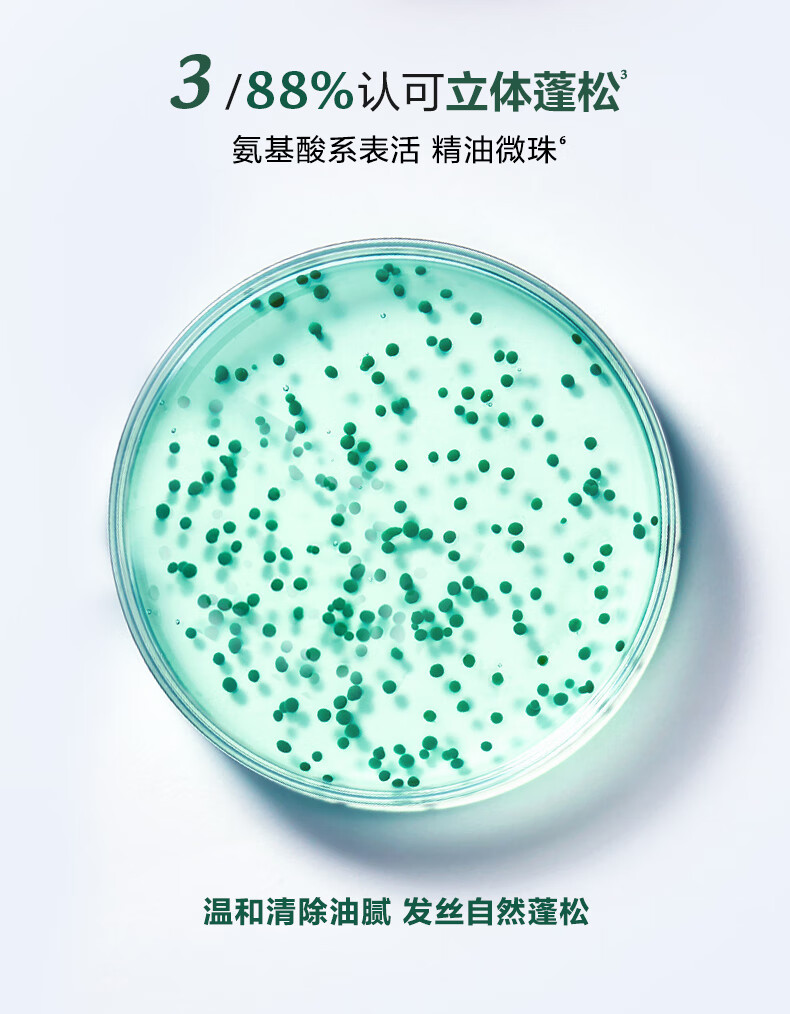

馥绿德雅(RENEFURTERER)赋活焕能控油洗发露600ml(控油强韧 清爽无硅油 防断掉发)法国
| 原价 | |
| 价格 | ¥ 308.0 |
运费:包邮
热销:70 件
| 领券 | 券¥ 10 |
| 数量 | 库存284件 |
| 立即购买 加入购物车 |
新品推荐
笼趣复古家用针线盒婚嫁手工缝衣服修补工具缝纫便携包线盒木质针线盒(熊猫款) 24色线
¥51.0
已售95件
针线盒家用针线盒实木针线包小工具便携多功能缝衣针线套装学生宿舍实木针线盒(空盒)
¥29.0
已售36件
热销排行
为伴暖贴宝宝贴发热贴 暖身贴保暖贴热帖 暖贴宫暖大姨妈贴 暖膝贴20片加大款
¥49.0
已售100件
赫牧墙纸自粘 墙面贴纸装饰壁贴桌面柜子改色墙贴防水防潮即时贴餐厅背景墙翻新贴膜纸 天蓝-60宽X3米
¥26.0
已售100件
景德镇陶瓷器挂盘装饰摆件创意小礼品家居饰品客厅电视柜酒柜装饰工艺品办公桌摆 26CM鸿运当头盘 龙架
¥29.0
已售100件
方象迷你缝纫机家用 多功能家用小型电动缝纫机自动脚踏衣车便携式吃厚微型家用锁扣眼衣车台式 10件套大号针线盒
¥29.0
已售100件
毕业礼物生日礼物送男生中高考加油祝福礼物一帆风顺帆船摆件模型一帆风顺帆船模型(带灯) 【扬帆起航,追逐梦想】
¥37.8
已售99件